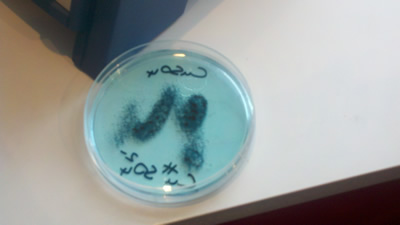

Filed under: Dublin
The girls love a picnic! So on Saturday we trekked down to Kilmainham – one of the best gardens in Dublin. Patrick called it in the heart of Dublin – I might not go that far – but it’s pretty close to town. And it is beautiful. We had a nice picnic, walked through the gardens and popped into the Irish Museum of Modern Art. We saw a really interesting video by Orla Barry. Patrick doesn’t like modern art – but I drag the girls to a lot of modern and performance art stuff because I like it. Well it all paid off when I had to eventually drag them from a video by Orla Barry – about a man who wanted to live on an island and a girl who appeared to live in a cemetery.
After we walked into town along the Liffey. The Liffey can be a little rough looking in places – but it’s always a good walk.
Filed under: Dublin
Last week I dragged Patrick to the Science Gallery for a great DATA 47.0 event. There were three speakers who worked on techie, cutting edge performance arts stuff. The first was Teresa Dillon who worked on performance arts pieces in off-site locations where the scenes or acts seemed to be triggered by the audience. The audience members had RFID trackers that triggered the action. Next was Duncan Speakman who spoke about silent flash mobs or “lazy film making” where audience members are each given an MP3 – but they receive different MP3s. SO some may hear a narrative, while others are hearing instructions to perform acts (like shake someone’s hand) that would in effect lead them through acting out the stories that the other audience members are hearing.
Also he has used technology (cell phones, Google maps and an artist at a remote site) to lead individual residents through a conversation/tour of their city. Where the residents might talk out loud about what they would like to see happen (in terms of urban development) in various areas. While the residents talk, the artists work away to draw out the visions described. Then the residents convene – a map is created with the artist renderings of the ideas and talk together about their visions – making they cases as to why their visions would make sense.
Finally, Peter Petralia spoke about a project in Bristol where they had sort of a scavenger hunt that involved about 100 volunteers. People signed up, not knowing what was going on. Then for two weeks then received emails, texts, letters and phone calls inviting them to different tasks. If they were available – they participated. The participants interacted in the various tasks, which often involved some use of social media to track their impressions and thoughts.
So I have to say that all of the ideas sounded super interesting to me. Makes me wish I could participate or even lead something like that. Can you imagine anything better than a techie scavenger hunt that goes on for a week?
Filed under: Dublin
Last time we were here the girls and I spent a big day in Howth – including a boat out to Ireland’s Eye and a big hike. This time we went specifically to feed the seals. Sadly you can’t feed them anymore! We were crushed. Apparently the fee is up to 5000 euros – and the shops that used to sell the fish for seals no longer do it.
The good news is that you still see a lot of seals and we had a nice lunch. Although we were surprised to see that the Mussels and Frites did not include French fries. The very new waitress was a little surprised to hear that frites was French for French fries. (Regardless we ate French Fry-less.)
Filed under: Bray
Earlier this week we all trekked to Bray. We were trying to think of some fun things to do before we headed home. Bray is always good because they have a video arcade sort of a place and the beach front. Plus the Bray Fest is going on right now so there were carnival rides too.
So we started with a turn at Fun House. Or the kids did anyways. Then we hung out on the beach. It wasn’t warm enough for most of us to wear our swimsuits – but it was plenty hot for Aine as you’ll see. For the rest of us it was more fun to skip stones and look for shells rather than get wet.
Then we thought we’d hop up to the top of the Bray Head. I didn’t quite realize what we were getting into at the onset. You might notice in the picture (or if you can picture Bray yourself) that there are three bumps on the top of Bray Head. On the first bump is a cross – we climbed up that high. It starts out very easy – but really it’s a big climb. The view from the top is amazing!! Although I spent most of the time shouting at Aine – Get away from the edge. Quit walking to the cliff. Stop trying to run down the hill! Just quit moving. It was a fine combination of my abject fear of heights and Aine total disregard for gravity.
One the way up the hill we saw a hill runner on his way down. The hill/mountain runners just run straight down the hill. That was an idea that Aine liked. She really wanted run down too. There were a couple of key differences – starting with the fact that she was wearing flip flops. And not just any flip flops – flip flops that are broken so that they fly off all of the darned time. By the end of the trek even the girls were yelling at her. We don’t yell at Aine that often – but we were all afraid of making the news!
Anyways – we survived. And when we got to the end of the road we popped into the arcade to play the 10p machines. Well, they’re 20 cents machines now. Those are the machines where you try to knock coins off one shelf, onto another and into your hands. The first time I saw them was a Quadrophenia pilgrimage to Brighton, England. I could play those for hours!
Filed under: Dublin
Last Sunday we had lunch in a fancy restaurant in a mall. It was nice – then we had a fun side trip to Tully Church. Tully Church is near to the house. I had been there before. Patrick and I walked there last the time we were here – but we had to get past a horrible, mean barking dog to get there. But on Sunday we had a car.
Cross at Tully Church is from the 12th or 13th century. Then there’s a church that’s probably older; I think they say 9th century. They’re kind of fun to see and climb on. It’s fun to see the landscape in the area too. As Lily said it would be fun to see a picture taken every year from the location – you could have seen a lot of building over the last few decades.
For extra credit Patrick and I took a walk Monday morning in the opposite direction to a dolmen in Ballybrack. Dolmens are rock formations that are burial portals. It’s kind of amazing to see all of the ancient religious building in the area. There’s a web site called Megalithic Ireland that I sometimes visit when I feel like taking the girls on a boondoggle walk.
Yup just a regular Saturday for us – Zombies, Breakdancing, Roller Girls and more. Actually even for us last Saturday was a pretty full day. We started with the Dublin Zombie Walk in Stephen’s Green. There must have been thousands of zombies – it was great. Some people clearly spent hours on their makeup and costume. We spent quite a few minutes.
There were at least two highlights from the zombie tour. First it was great to see the zombies attack the buses. They just left trails of blood all over the buses and you could see that the people on the bus had no idea of what was going on. Then the zombies attacked St Ann’s Church on Dawson Street. It’s where Bram Stoker was married. Also it’s kind of a creepy looking church in its own right. Very cool to see the zombies against that back drop.
We left the zombies march after half an hour or so to see the Graffiti and Breakdancing Festival. It has grown in the last two years! The graffiti was great. We heard some great music – depending on who you ask. (Some people are old before their time!) The girls got to try Mountain Dew plus, which we later read was not for under 18s. I’m sure the extra surge was good for Aine.
Then a quick trip to Reptile World. Our friend John (who was with us) knows the owner, who unfortunately wasn’t there. Well I say unfortunately, but I don’t mean it. I feel we would have been even closer to the snakes and creepy crawlies than I ever want to be had he been there.
Then off to Greystones for the Roller Girls. Roller girls in Dublin is different. It’s much newer here – so the skating isn’t as good as back home. It’s more like the skating in St Paul was a few years ago. But the skating in Dublin is tough! The jammers try to knock each other over. Lots more hip checks than I remember in MN. Also the bout was in a gym – not the Roy Wilkins. I suspect that in a couple of years they will have moved into a better (read cooler) location – closer to the city and in a night club setting versus leisureplex.
(In fairness Greystones is beautiful and the trek out there was very pretty.)
Finally, we headed back to Cabinteely where there was an outdoor ceili dance. It was good – lots of local food vendors, music and plenty of people.
Then we fell into bed!!
Filed under: Dublin
It’s kind of a funny mix – but yesterday we wet to the Rose Festival and the Viking Festival in St Anne’s Park, which is on the other side of the harbor from us. I know this will be meaningless to most readers – but for my friend in the know…We made a tactical error on the journey and got off the DART at Contarf – then we walked down the coast road to the park. So that added about 3 miles to the beginning of our day. (You can take ‘em out of the South Side – but not help them read a map.)
Anyways we were very lucky with the weather on the walk to the park. And fortunately I really like to walk and the rest of the posse will sort of follow without much complaint – but we were happy when we finally got there. The Rose Festival was really a series of booths – inclduing some very delicious food. We walked around. We watched a band for a while. Aine did a craft project. We saw some very pretty roses. Patrick bought books.
The just a few yards away really – was the Viking Festival. The big deal was reenactment of the Clontarf Battle. For those who didn’t attend (or pay that much attention in history class) …
The Battle of Clontarf (Irish: Cath Chluain Tarbh) took place on 23 April 1014 between the forces of Brian Boru and the forces led by the King of Leinster, Máel Mórda mac Murchada: composed mainly of his own men, Viking mercenaries from Dublin and the Orkney Islands led by his cousin Sigtrygg, as well as the one rebellious king from the province of Ulster. It ended in a rout of the Máel Mórda’s forces, along with the death of Brian, who was killed by a few Norsemen who were fleeing the battle and stumbled upon his tent. After the battle, Ireland returned to a fractious status quo between the many small, separate kingdoms that had existed for some time.
We saw the reenactment, which was kind of fun. It was also kind of fun to hear the cheers and jeers from the audience. It was all good natured – but funny. They recreated the battle three times – demonstrating three battle approaches. The funny thing was that once the actors were dead – the emcee would “call to Valhalla” to revive them for next variation on battle
On the way home we got caught in a serious downpour. It’s been raining ever since.
See our other videos:
http://www.youtube.com/watch?v=S78K4dSoH58
http://www.youtube.com/watch?v=wka2xIeCOCA
Filed under: Dublin
This week is the Made in Temple Bar Festival. Temple Bar is an area in Dublin. It’s kind of arty by day – kind of rowdy and a favorite haunt of bachelor and bachelorette by night. The arts line up for the festival is great – sadly we weren’t able to get tickets for most of the events – but we were able to see the tightrope walker. You’ll see the from video it was kind of cool. Went with the kids and our longtime friend John. A good end to a good day. (Forgot to add that before the tightrope walker – we heard Aidan Walsh sing a few songs. He’s sort of a character around the Dublin music scene.)
See the other very quick video: http://www.youtube.com/watch?v=RJhr9li_ktk
Filed under: Dublin
The Science Gallery, one of my favorite places in the world, had been closed since we’ve been here – preparing for the latest exhibit: Elements. It opened on Friday. It was great as we knew it would be.
The Science Gallery does take a few minutes to warm up to. The exhibits are done primarily by students at Trinity and the students are the docents. Some are better with kids than others. (While the summer show is usually very kid-friendly, not all of the shows target or are remotely interesting to kids.) Here are some of the things we got to do:
- Find out what elements we contain. You step on a scale sort of thing and they’ll tell you how much of your body is oxygen or tin. You walk away with a big sales receipt sort of list.
- Aine got to make a rock garden. We didn’t keep it but it was cool and very fast growing.
- I separated copper from iron
- Lily & Aine got electricity from lemons
Filed under: Dublin
Last Thursday Patrick’s advisor Tony Roche had a book launch for his latest work – Brian Friel: Theatre and Politics. Tony has always been supportive and Patrick and very kind to us. SO we were invited to the launch. Lots of the Irish Literatti were there. The big highlight was that Brian Friel himself was there. Patrick got to meet him – and we have the picture to prove it.